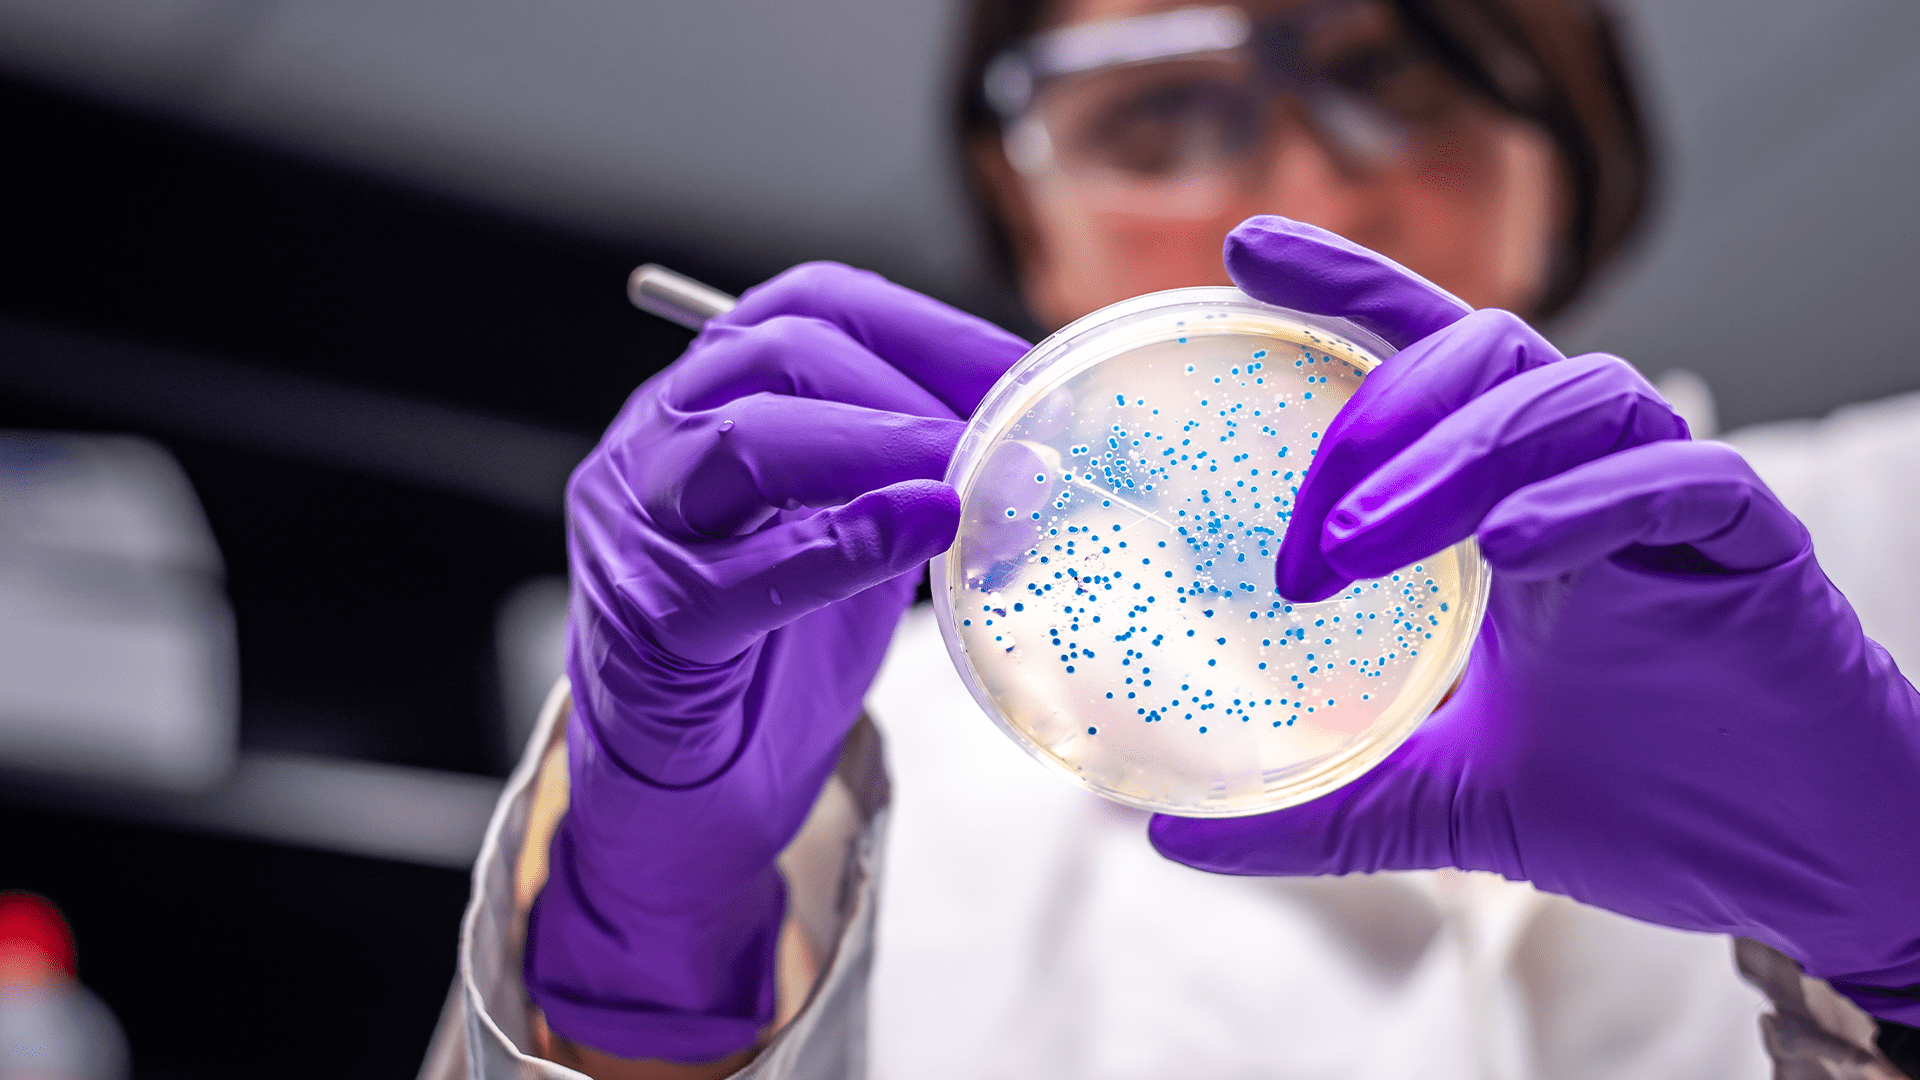
Researcher wearing laboratory glasses holding a Petri dish and stirring the culture with tweezers

All information about applying for this Master's Degree can be found on the website of the Instituto Superior Técnico (IST).
Master
Microbiology
The Master's Degree in Microbiology offers modern and competitive training in microbiology. Its programme focuses on the study of microorganisms, which is essential for understanding the fundamental mechanisms of life and enabling new developments and applications in industrial biotechnology, environmental recovery and energy production, human and animal health, and the food sector.
This is a joint master's degree, taught by a consortium of four schools at the University of Lisbon: Sciences, Instituto Superior Técnico, Medicine, and Veterinary Medicine. This programme thus explores the synergies that have become possible at the new University of Lisbon in terms of teaching, research, and connection to society.
Useful Information
September
ULisboa Campus
2 years (4 semesters)
120 ECTS
Daytime
25
How To Join
1st period: 9 March - 20 March 2026
2nd period: 22 June - 3 July 2026
More information available at https://tecnico.ulisboa.pt/en/education/courses/masters-programmes/microbiology/
Bachelor's Degree or equivalent in Life and Health Sciences, Biotechnology and Engineering (if it includes a biological component) and related areas.